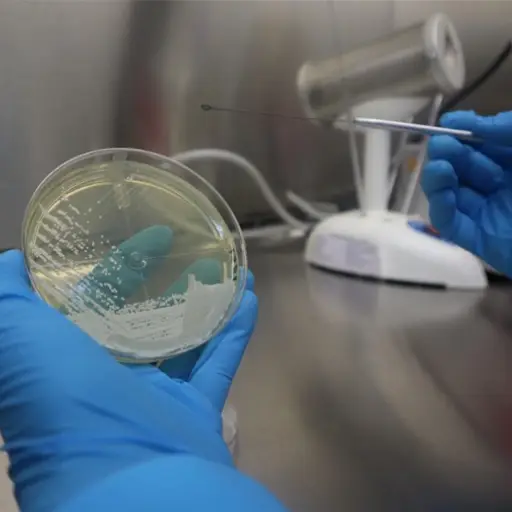
Foto: Ministerio de Salud

hongo
Nacionales
Salud emite alerta por hallazgo de Candida Auris en Guatemala
- por Nancy Alvarez
- 05:16 PM, Feb 11
En Portada
Temas
×

¿Activar notificaciones?
Recibe las últimas novedades directamente en tu dispositivo.